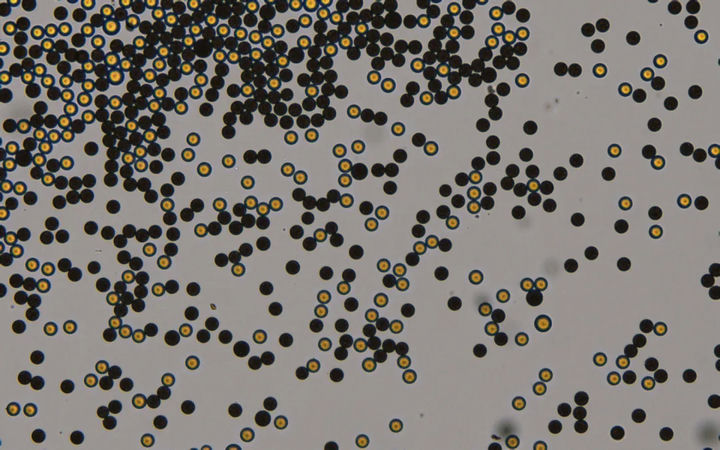
896e25bb7a06b2584f7ad74449e197bf-sz_1171224.jpg 896e25bb7a06b2584f7ad74449e197bf-sz_1171224.jpg

倒置荧光显微镜MF52-N应用于荧光微球观察
荧光微球是一种在微观尺度上发光的球形颗粒,常被用作生物医学研究的标记物。它具有易于观察、稳定性好、可大量制备等优点,因此在免疫学、细胞生物学、药物筛选等领域得到广泛应用。

在倒置荧光显微镜MF52-N下,荧光微球呈现出令人惊叹的景象。微小的球体在激发光的作用下发出鲜艳的荧光,这些微小的发光体仿佛是微观世界中的繁星,为研究工作增添了无尽的魅力与神秘。通过调节倒置荧光显微镜MF52-N的参数,我们可以观察到不同大小、不同颜色的荧光微球,甚至可以观察到微球与细胞或其他生物样本的相互作用。


荧光微球在诸多领域展现出巨大的应用价值。例如,在免疫学研究中,荧光微球可以用于标记特定的免疫细胞,以便于观察和分析其在疾病发生发展过程中的作用;在细胞生物学中,荧光微球可以用于标记特定的细胞器或细胞表面受体,以便于研究其在细胞生命活动中的作用;在药物筛选中,荧光微球可用于评估药物对靶点的作用及副作用等。
Mshot 明美LED倒置荧光显微镜MF52-N搭配上Mshot 明美高灵敏度的荧光显微成像系统(MSX2/MS23/MC50-S等)为荧光微球的观察和记录提供了高性价比和高效率的整体解决方案。LED荧光的即开即用,随开随关,亮度可调,亮度记忆等功能让荧光微球的观察和记录变得格外轻松。欢迎垂询!
免责声明
本站无法鉴别所上传图片、字体或文字内容的版权,如无意中侵犯了哪个权利人的知识产权,请来信或来电告之,本站将立即予以删除,谢谢。